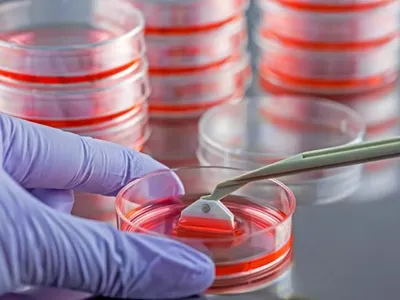

O tânără de 24 de ani, licențiată în bioinginerie, are o poveste ce trage multe semne de întrebare despre societatea de astăzi. Ea a renunțat la doctorat și la visul de a deveni profesoară și s-a dedicat creării de conținut pentru bărbați. În primele 3 luni, a făcut 50.000$.